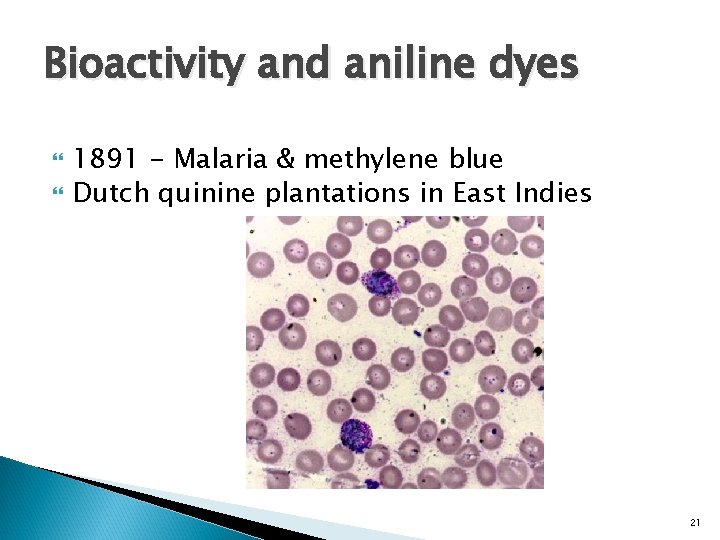
Bioactivity and aniline dyes 1891 - Malaria & methylene blue Dutch quinine plantations in

HSTCMP 410 A Medicine History Society Medicine Industry

- Slides: 57
HSTCMP 410 A: Medicine, History, & Society Medicine, Industry, & Imperialism July 21, 2016 Laura Harkewicz, Ph. D. 1
Today’s agenda Recap Dyestuffs industry Paul Ehrlich & chemotherapy Medicine, molecules & industry The laboratory as imperial project 2
Recap Medical laboratories France & Germany in mid-19 th c. Investigated physiological processes metabolism Bacterial microbes were identified & controlled for virulence World as laboratory Vaccines – therapeutic application of laboratory 3
Aspirin First marketed - 1900 Wonder drug 4
Origins in White Willow (Salix alba) Bark Ancient remedy Analgesic - painkiller Folk remedy in medieval times 5
Edward Stone (1702 – 68) 1758 – tasted leaf of white willow Powerfully bitter Reminded him of cinchona bark Gave to fever patients 6
Scientific pharmacology By end of 18 th c. – scientific pharmacology 1804 – opium Nicotine, strychnine, caffeine, quinine followed 7
Aspirin pharmacology 1828, Joseph Buchner (1813 – 1879) extracted yellowish, bitter crystals Named it “salicin” – Latin for “willow” – later renamed “salicylic acid” Meadowsweet isolated - same substance. Medically potent, severe side-effects 8
Dyestuffs Industry Provided materials & infrastructure Systematic investigation Novel compounds for industrial activities = origins of modern pharmaceutical industry 9
Coal-tar By-product of new coal-fired industrial economy Produced when coal is carbonized to make coal gas. Complex chemical compound Different distillations produce all sorts of useful substances 10
Coal tar to creosote to carbolic acid Creosote Carbolic acid Coal tar is still used Aniline dyes = most imp. coal tar derivatives 11
William Perkin, dyestuff, & the origins of the pharmaceutical industry Perkin (1838 – 1907) – chemistry student in London Worked under August von Hofmann (1818 – 1892) 12
From medical analysis to dye industry Around 1856, Perkin started to work with coal tar Possibly bioactive (having effect in living organism) Set up a dyestuffs factory 13
From dyes to medicines 1886 – naphthalene to treat for intestinal worms. Mix-up with the order Patient received a common by-product of the coal tar industry Acetanilide - very common Renamed it “Antifebrine” Made lots of money 14
From dyes to medicine, cont. Carl Duisberg (1861 – 1935) – a chemist working at Friedrich Bayer dyestuffs company – developed an anti-pyretic from dye waste Named it “Phenacetin” Influenza epidemic - insured sales 15
The invention of aspirin Felix Hoffman (1868 – 1946) Developed basic chemistry of aspirin (acetylsalicylic acid) “Heroin” 16
Paul Ehrlich (1845 – 1915) Histological staining 17
Importance of histological staining Exploited chemical properties of new aniline dyes Some components stained, others uncolored Ehrlich - selective action of aniline dyes 18
Receptors and Chemotherapy “Dock” “Receptors” “Chemotherapy” v. “Immunotherapy” 19
Ehrlich’s concept of “Magic bullet”: The perfect drug to cure a disease with no danger of side effects 20
Bioactivity and aniline dyes 1891 - Malaria & methylene blue Dutch quinine plantations in East Indies 21
Ehrlich’s Arsenic Investigations With the support of the huge corporation I. G. Farbenindustrie (“color industry”), in 1907, he engaged in a search for a drug to treat syphilis Arsenic Ehrlich systematically tested 22
Sahachiro Hata (1873 – 1938) In 1909, Japanese chemist Sahachiro Hata joined Ehrlich Introduced animal testing of chemicals to the laboratory 23
The Breakthrough 606 th compound - shown to be effective in vivo Began human trials Good results Announced the cure at an international medical congress in 1910 24
Problems with Salvarsan (salvation thru arsenic) was unstable and unpredictable Intravenous technique was still not standardized Only safe when used at exactly the right dose and right phase of its chemical breakdown 25
From lab to market Let’s review the steps discussed here together…. . 26
Break 27
The laboratory as part of the Western European Imperialist project 28
Imperialism The extension of political control from one region to others with different cultures/languages/ ethnicities 29
Connections between Medicine & Imperialism: 1) Modern medicine made European expansion possible – enabled survival 2) European expansion vector for the spread of modern medicine 30
Tropical Medicine Around 1900 Bacteriology integral For medical protection of their nationals (the colonizers) & control over the people & environments they were mastering (the colonized) 1899 - Mc. Clure’s, Rudyard Kipling (1865 – 1936) - Spanish-American War (April – Aug. 1898) …. 31
“Take up the White Man’s burden The savage wars of peace – Fill full the mouth of famine And bid the sickness cease. ” 32
In this way of thinking, the “superior” white race was burdened by the need to “save” other races from disease, lack of education, and other “primitive” qualities. Disease = burden to progress. 1890’s soap advertisement teaching virtue of hygiene to other races 1898, The Journal, Detroit – Building in back says “School House” 33
Scientific Medicine & Authority - objectivity, rationality, dispassion (e. g. being scientific) Scientific medicine = Western medicine (includes Western ideals) Scientific v. “nonscientific” - arbitrary, irrational, misguided, ineffective, etc. 34
Malaria, the Asante Campaign, and the spread of the British Empire Modern Ghana, the Asante Empire had established its military and economic dominance Established large urban centers, agricultural surplus, trade in gold, ivory, and slaves 35
British empire and Asante empire fought a series of wars over the course of the 19 th c. Asante were often victorious African soldiers generally immune to malaria and yellow fever, but smallpox often affected them. British were affected by both malaria and yellow fever. 36
Florence Nightingale & the reform of military medicine In the 1850’s, Florence Nightingale went to the Crimean peninsula to nurse British soldiers fighting against Russians She advocated ventilation, cleanliness, better nutrition, and quinine Florence Nightingale (1820 – 1910) 37
Military Medicine after Nightingale In the 1860 s after Crimean War (1853 – 1856), reform military medicine Asante campaign of 1869 38
“The Asante campaign was the doctors’ war, perceived as the first evidence that modern medicine made it possible for European troops to act safely in the tropical world. ” 39
In 1874, 2500 quinine-dosed British troops were marched from the Atlantic to the far reaches of the Asante empire w/o serious loss of life “Double imperialism” 40
Tropical medicine & “tropical” diseases Late 19 th c. Microbe hunters Research on malaria, leprosy, yellow fever, bubonic plague, etc. Patrick Manson (1844 – 1922) – tropical diseases could involve parasites & vectors 41
Manson’ breakthrough Elephantiasis – (see image at RT) Caused by a nematode worm, Filaria 1877 - gnat, Culex fatigens Significance: Insects and disease 42
Malaria beyond quinine In 1888, Alphonse Laveran (1845 – 1932) recognized the malaria plasmodium in its first stage of sexual reproduction Manson’s hunch In 1894, he shared his thoughts with Ronald Ross (1857 – 1932) 43
Ross’ experiment Discovered Plasmodium in the stomachs of Anopheles mosquitoes that had bitten malaria sufferers Parasitological model provided the prospect of malaria control through mosquito eradication But no cures 44
Yellow fever Mosquito Aedes aegypti - Cuban physician Carlos Finley (1833 – 1915) in 1881 1900 - U. S. Army Yellow Fever Commission was established Headed by Walter Reed (1851 – 1902), from Johns Hopkins Hospital, & James Carroll (1854 – 1907), from the U. S. Army Medical Corps 45
The Yellow Fever (Reed) Commission Researchers became own experimental subjects While Reed was away, Carroll & researcher Jesse Lazear (1866 – 1900) allowed themselves to be bitten by infected mosquitoes Both got sick Carroll survived Lazear did not American soldiers volunteers 46
The Experiment Volunteers were split into two groups: The first lived among the clothing & bedding of yellow fever victims The second were put in isolation & then bit by mosquitoes infected by yellow fever patients 47
Results Not one of the first group got the disease But 80% of those bitten by infected mosquitoes became ill All survived 48
The Panama Canal Construction abandoned by French because of fever Example of tropical medicine’s power to aid civilization 49
The Reed Myth Reed - symbol for the heroic selfsacrifice of scientific physicians 1930 s, – Yellow Jack 50
The Reed Legacy Walter Reed General Hospital (WRGH) opened in Washington, D. C. in 1909 Walter Reed Army Medical Center – the successor to WRGH – opened in 1977 Walter Reed Medal was established by an act of Congress in 1929 51
Bubonic Plague Caused by rodshaped bacterium transmitted from rodents to humans by fleas Bacterium, Yersis pestis, named for Alexandre Yersin Yersis pestis 200 x magnification 52
Alexandre Yersin (1863 – 1943) Preferred dangers & discomforts of exotic travel to the boredom of laboratory life Signed up for duty as ship’s doctor in French Indochina Developed sideline in exploration and cartography, hacking through miles of jungle, battling pirates, leeches, and anticolonial rebels 53
1894 – sent to Hong Kong during outbreak of bubonic plague Set up straw-bale laboratory next to hospital Isolated bacterial agent responsible for disease 54
Microbiology & Imperialism Public policy driven less by clear sense of plague etiology than by incomplete knowledge and preconceived notions about Chinese habits American physician Burnside Foster wrote towards the end of 1894. . . 55
“The malady is undoubtedly a filth disease and caused by a bacillus. . . It has been wellnamed “the disease of barbarism, ” from the fact that it only occurs among the semicivilized. There is little to be said concerning treatment. ” 56
Reinforcement of imperialistic attitudes Massive cleanup campaigns “Scientific” v. “superstitious” Callous (British imperialists ) v. compassionate (Chinese elites 57